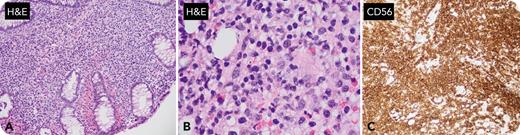
graphic

A 58-year-old woman undergoing colonoscopy was found to have a 1-cm colonic polyp. Histologically, there were normal colonic crypts with an underlying dense lymphoid infiltrate composed of atypical medium to large cells with paranuclear granules expanding the lamina propria. The cells stained positive for CD2/CD3/CD56, T-cell intracellular antigen 1, and granzyme B, but not CD5/CD4/CD8/CD30, T-cell receptor (TCR) αβ/γδ. Ki67 was 30%. Epstein-Barr virus (EBV) RNA in situ hybridization (ISH) was negative along with polymerase chain reaction (PCR) negative for monoclonal TCR-γ gene rearrangement (panel A: hematoxylin and eosin [H&E] [original magnification ×20], panel B: H&E [original magnification ×50], panel C: CD56-immunohistochemical stain [original magnification ×20]). Further workup was needed to exclude potentially aggressive natural killer (NK)/T-cell lymphoproliferative disorders with CD56 coexpression such as monomorphic epitheliotropic intestinal T-cell lymphoma (MEITL) and extranodal NK/T-cell lymphoma. The lack of TCR γ/δ expression and of clonal TCR gene rearrangement helped to exclude MEITL, and the lack of EBV excluded extranodal NK/T-cell lymphoma. Follow-up studies (bone marrow biopsy, blood flow cytometry, positron emission tomography, and computed tomography) were normal, along with further imaging and colonoscopy over a 2-year period, leading to the consideration of indolent entities: indolent T-cell lymphoma of the gastrointestinal tract, and indolent NK-cell lymphoproliferative disorder of the gastrointestinal (GI) tract (iNKLPD-GI).
iNKLPD-GI was diagnosed, supported by the immunohistochemistry, ISH, and PCR, along with the indolent clinical course, which mirrors the new World Health Organization tumor classification’s description of this disease. Though rare, it is important to consider such a diagnosis to avoid unnecessary treatments for patients with this diagnostically challenging but indolent disease.
For additional images, visit the ASH Image Bank, a reference and teaching tool that is continually updated with new atlas and case study images. For more information, visit http://imagebank.hematology.org.

This feature is available to Subscribers Only
Sign In or Create an Account Close Modal